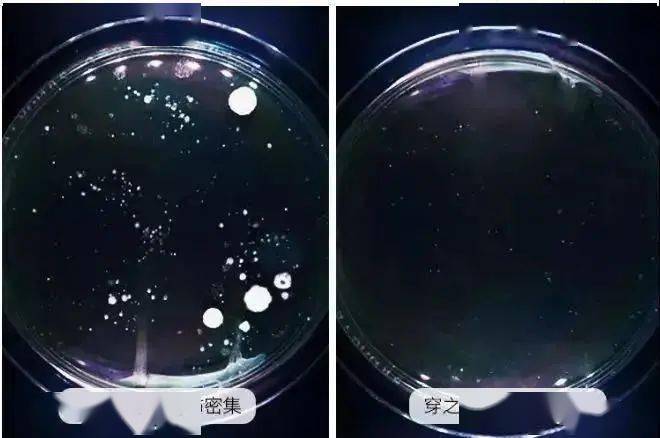
秘密|性开放的日本,为何妇科问题全球最低?秘密竟然是...

秘密|性开放的日本,为何妇科问题全球最低?秘密竟然是...( 二 )
文章图片

文章图片
市面上绝大部分内裤都是使用化纤面料 , 多洗几次底裆就会发黄发硬 , 更别提无形的棉絮飞到阴道里 , 会影响粘膜造成感染 。

文章图片
石墨烯抗菌内裤特别好的一点:
裆部使用了 100%纯棉进行制作 , 大身面料也是95%纯棉加上5%氨纶增加内裤的弹性,达到无可挑剔的亲肤性 。

文章图片
穿过它的女人都说:“从来没体验过那么舒服的内裤 , 清爽透气完全不闷 , 是全新的感受 。 ”
而且外观的样式设计也十足让人喜爱 。
腰头处加以银丝包边蝴蝶结点缀 , 小心机设计如同漫天的甜蜜被包裹至此 , 十足的少女情怀 。

文章图片
包边处选用 镂空蕾丝往下沿 , 极具分寸感的包边让穿着时不露痕迹也不卷边 。
脱下时带着 丝丝少女感幻想,蕾丝点缀又弥漫着性感绵延 。

文章图片
讲究的极薄包边让你穿上包臀的白裤子也是隐形超人 , 拒绝“透明”尴尬 。

文章图片
我们知道内裤的细菌主要集中在底 裆 , 特别遇上阴雨天 , 内裤天天潮湿难干 , 更容易滋生霉菌等细菌 。
市面上很多声称抑菌的内裤 , 其实只是把抑菌剂注射在面料表层 , 洗一次就没有了 。

文章图片
而这款石墨烯内裤 ,是将含有石墨烯的成分和底 裆面料一同生成 。 |
而它的底 裆结构非常细致 , 三层抑菌层层抵御 。 在贴合的第一时间就会把细菌抑制住 , 将细菌入侵的风险降到最低 。

文章图片
这款遇湿就会变成蜂窝状的石墨烯底 裆 , 遇到水份马上 分散吸湿 , 加速变干 。

文章图片
将石墨烯穿在内裤上 , 不但能预防妇科细菌滋生 。 即使分泌过多的白带、垃圾被排泄到裆部 , 也能被轻松分解、消化 。 保持私处的清新干爽 , 让私处保持健康 。

文章图片
虽说和化学成分有同等抑菌实力 , 但又比一般化学成分 对私处更加友好 , 是一条真正适合女性穿的抗菌内裤 。
踏踏实实的减少细菌滋生 , 给私处长效保护 。
文章图片
长效抵御病菌侵害 , 为娇弱处筑起安全「城墙」 , 摆脱瘙痒红肿异味豆腐渣 。

文章图片
水洗50次 , 抗菌力依旧稳定禁得住检测!
污渍、姨妈血、尿液、分泌物轻轻一搓就掉了 , 避免细菌滋生和二次感染 , 紧贴私处的内裤 , 时刻保持干净清爽 。

文章图片
线上购买过的客户更是好评如潮 , 纷纷表述一条内裤可以做到如此柔软、亲肤、透气 , 还“颜值视觉感十足” , 买过的用户不仅自己回购 , 也会推荐给身边的小姐妹 。
以上关于本文的内容,仅作参考!温馨提示:如遇专业性较强的问题(如:疾病、健康、理财等),还请咨询专业人士给予相关指导!
「辽宁龙网」www.liaoninglong.com小编还为您精选了以下内容,希望对您有所帮助:- 明煊 2022你该换个微信头像了,33张新款3D励志个性签名头像,请查收
- 魅力 粉色露脐T恤搭配瑜伽短裤,清爽性感有魅力,这样的穿搭风格你喜欢吗?
- 花色 吉克隽逸越来越会穿,豹纹皮草配吊带裙,真是狂野又性感
- 大衣 三四十岁的女人应该拒绝平庸,5种知性优雅的穿搭,更时髦提气质
- 个性 霍思燕真的很时尚,内衣外穿显个性,品味确实很独特
- 个性 霍思燕真有贵妇范,穿小黑裙披西服外套很高级,网纱羽帽更别致
- 蓝色 刘亦菲罕见玩性感,穿蓝色礼裙妩媚大方,神仙姐姐太有范
- 黑色 窦靖童也太潮了吧,剪“三毛头”穿印花裤,个性张扬太像王菲
- 气质 细跟尖头高跟鞋,穿出精美的女人气质,绽放出性感的一面!
- 优雅 尖头高跟鞋,更是集优雅和性感于一体
